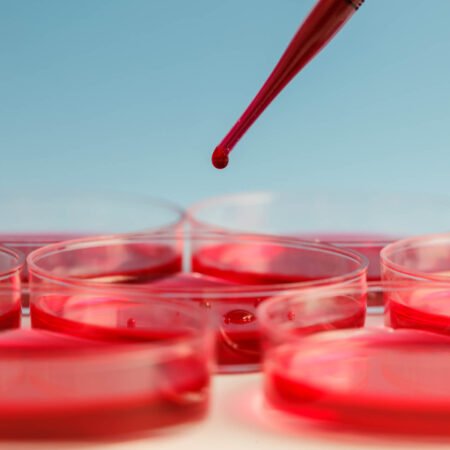
maxresdefault

Haqqımızda
Keyfiyyətli xidmət göstərə bilməyimiz üçün əvvəldən qəbula yazılın
2006-ci ildə Azərbaycan Tibb Universitetinindən məzun olmuşam. 2008-2013- cü illər arasında Marmara Universiteti Xəstəxanasında kardiologiya ixtisası üzrə uzmanlıq təhsili almışam.
- Ətraflı müayinə
- Erkən diaqnoz
- Hərtərəfli müalicə
- Ömürlük nəzarət

Dr. Fuad Samadov
Kardioloq
Xidmətlərimiz
Sağlamlığınız bizim xidmətimizdə
Təqdim etdiyimiz xidmətlər haqqında ətraflı məlumatı burada tapa bilərsiniz.

Ağciyər hipertenziyası
Ağciyər hipertenziyası
Ağciyər hipertenziyasının dəqiq diaqnostikası və səbəbinin müəyyənləşdirilməsi

Ürək kameralarının kateterizasiyası
Ürək kameralarının kateterizasiyası
Bu müayinə ürəyin ayrı-ayrı kameralarında, həmçinin ürəkdən çıxan…

Ətraflı Exokardioqrafiya

Stress exokardioqrafiya
Stress exokardioqrafiya
Mərkəzimiz ölkəmizdə bu müayinənin aparıldığı nadir klinikalardan biridir.

Transezofagial exokardioqrafiya
Transezofagial exokardioqrafiya
Normal exo müayinəsində şübhəli məqamlar qaldıqda daha ətraflı…

Ürək çatışmazlığı
Ürək çatışmazlığı
Ürək çatışmazlığı xəstələrinə tibbi xidmət prinsiplərimiz aşağıdakılardır:

Kardiomiopatiyalar
Kardiomiopatiyalar
Kardiomiopatiyalar ürək əzələsinin müxtəlif səbəblərdən yaranan xəstəlikləridir.
Team
We draw on our global network to assemble a team of experts.
We also bring a strong interest in coaching and capability building, with an emphasis on emotional intelligence and effective stakeholder relationships.
Collaborate Consulting exists to find the place where to being seemingly disparate interests meet. From that point of the connection, we create platforms.
Call Now for any help!
(281) 476-0713
Blog
Some from our latest news
We would love to share a similar experience and how I
learned some valuable lessons during a downturn.